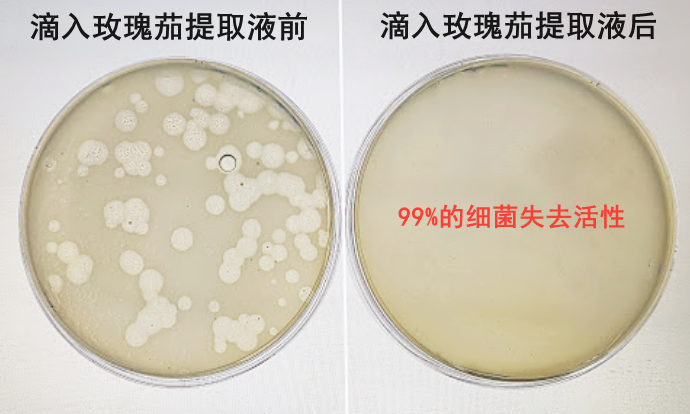

如何1秒引发“社会性死亡”?
答案是:口臭!
口臭这件事最可怕的是:你自己闻不到,而别人一靠近,就能很明显的闻到!

口臭的人连呼吸都是错的!一张嘴就能让所有人嫌弃:同事躲着、朋友偷偷吐槽,就连爱人、父母、孩子都受不了!

但为什么口臭总是去不掉?刷牙/漱口没几分钟,恶臭又会卷土重来!
医学研究显示:其实99%的人都有过口臭。有的人是浅性口臭味道不大;而顽固口臭,又叫做深源性口臭,病因就来源于“胃里”!

现代人饮食习惯不好、胃肠功能普遍很差!肚子里长年累月淤积毐素、病箘,与胃酸发酵出腐臭味。臭味再上行回嘴里,就成了“去不掉的口臭”!

所以口臭就是胃肠发出的“求救信号”!如果长期忽视,毐素更会侵蚀胃黏膜,导致胃炎、胃溃疡!所以中医治口臭,向来都是从胃根治!

比如主治口臭的中医方剂——《合香丸》,便是其中的代表!
服“合香丸”,吐气若兰
古书有云“遇一美姬,香气袭人”,指的就是杨贵妃——杨玉环,自带香气、呵气如兰;每有汗出,红腻而多香!

杨贵妃所到之处,香气袭人,连汗液都是香的!唐玄宗非常迷恋这种香气,对她可谓“三千宠爱于一身”!

她自带体香的方法,在入宫成为贵妃后,也成了“藏不住的秘密”!
宫女相传:贵妃常以洛神花、丁香等药草制丸,每日含一丸在口中。“5日口香,10日通体透香,27日衣被香,37日下风人闻香”!

此配方便流传于太医院,后记载于《古今医统大全》卷六十三中,名为《合香丸》。嘉靖帝还将它赠于日本使者,成为了日本最著名的汉方医典!

配方详细记载:菜菔子、玫瑰茄为君,桂花、洛神花为臣。辅以丁香、藿香、桂心,佐以肉豆蔻、白芷,蒸制研磨成丸。
服之去热毐气、调和腑脏,使人口体生香!

如今,现代中医传承并改良了《合香丸》!只需吃几粒,消灭胃部毐素垃圾,从源头去除口臭!
⬇ ⬇ ⬇
鸿蒙合香丸

每次3-5粒,嚼服或配温水吞服。上除口臭,下调肠胃!
9味草本修护胃黏膜、消灭胃部毐素、降火消炎!从源头去除口臭、清新口气一整天!还能舒缓肠胃不适、口腔炎症!

直达胃部源头 30秒去口臭
口臭的根源就在胃里!要想彻底告别口臭,必须先修护受损胃黏膜、排光胃部毐素!

配方中的“养胃仙果”肉豆蔻,据《千金方》记载:能修护受损胃黏膜、改善胃部环境,从源头消除口臭!

而菜菔子又有疏通胃气、排毐净浊的作用!《伤寒杂病论》中有云:“菜菔子净胃中之秽恶,使口中臭气尽除!”

成分中的丁香性温、归脾胃经,常用于治疗积食腹胀等不适。能增强胃部抵抗力,让毐素垃圾不再堆积!

每天简单吃点合香丸,胃部毐素消失、不积食、不便秘!从胃到口腔都干净,从此和口臭说拜拜!

上海刘女士:舅舅是中医院主任,推荐给我的合香丸太有效了!吃完舌苔不腻、不发黄,嘴巴不臭了!老公最近还夸我,说我嘴巴里香香的!

河南张先生:最开始只是口臭,后来就消化不良、胃溃疡了!中医开了一副合香丸,吃了一周期后,嘴巴真的不臭了!吃饭消化快了,胃病也轻了!

肠胃强健之后,便秘问题也会缓解!排便畅通、代谢快,大肚腩就像“泄气的皮球”!久违的好身材回来了!

山东钟先生:五年口臭+便秘史,吃进去排不出,还长出了大肚腩!老婆给我买了合香丸,吃了一段时间,口臭、便秘都解决了!大肚子也变平坦了!

只需一瓶古方合香丸,还你一个健康胃、彻底告别深源性口臭!还能解决便秘和大肚子!一举多得!

养护胃肠 根除口臭源头
溶箘除臭 满口清香 去火清热
原价:58 粉丝特价:49.9元
限时买2送1、买3送2,超值!
点击下方,立即抢购
消灭细箘 中和异味
医学研究表明:口腔中至少有上千种细箘!细箘与食物残渣发酵,会释放出多种难闻气味,这也是口臭的另一病因!

合香丸不仅能从内调养,更可以消除口腔细箘+快速中和异味!内外同修,效果立竿见影!

配方中的玫瑰茄,就是口腔细箘的“天然克星”!《本草纲目》记载:“玫瑰茄可除口之浊气,内服有香口之效!”

现代医学也表明:玫瑰茄中含玫瑰碱、茄酸,有很强的细箘灭杀力!是当之无愧的“口臭克星”!
广州李小姐:口臭很严重,仪器测试是非常臭的4级!吃完合香丸后,感觉从嘴巴到胃都干净了,口气也变成了清新的1级!

成分里的洛神花,含有大量挥发性花苷素,具有中和异味的作用!能快速缓解口臭,让你呼吸之间都是淡淡的花香!

古人云:“桂花,香气柔和悠长,十里之外皆可闻之!”不仅能中和口腔异味,还能长时间留香!让口气长久保持清新!

吃几颗合香丸,相当于用10瓶漱口水!30秒就能净化臭味,嘴巴24小时散发清香!让你从此远离社交尴尬!

工作面试和商务洽谈前吃几颗,口腔异味立马消失!每次说话都自信无比,让你的工作更上一层楼!

约会之前来几颗,嘴巴里就像喷了“香水”!亲密接触更大胆,让ta彻底沦陷在你的香气中!

清火解热 告别上火问题
现代人吃饭都很重口味,隔三岔五就上火!不仅也会导致口臭、口苦,还会引发牙龈红肿、嗓子疼、口腔溃疡等问题!

但这款合香丸中的桂心,自古就是中医界的“去火圣木”!《伤寒杂病论》也曾记载“桂心温寒驱热,能平五脏邪火!”

多种草本精华合效,也能缓解咽喉肿痛的问题!简单吃上1颗,火气肿痛全都消失,让你的嗓子轻松舒服!

广东林先生:每次口臭复发,嗓子都会上火红肿!同事推让我试试合香丸,吃完口气马上清新,第2天嗓子也不疼不肿了!

配方中还加入了一味藿香,有很好的收敛修复作用!能加快口腔溃疡愈合,让你告别“锥心之痛”!

重庆黄先生:我经常吃辣,不仅口气重还爱长溃疡!朋友推荐我试试合香丸,没想到吃了3天溃疡就好了!口气也清新了许多!

配方中又加入了白芷,具有去火散瘀、镇痛消肿之效!能快速缓解溃疡、牙龈红肿,刷牙/吃东西再也不怕疼、不出血!

山西刘女士:患上口臭后,牙龈超容易上火,啃桃子都会出血!后来吃了1个月合香丸,口臭和口腔上火都消失了!现在啃苹果也没压力!

干燥上火高发季+火锅流行的时代,身边常备一瓶合香丸!简单吃几粒,嘴巴不臭不上火,麻的辣的放心吃!

古法上品 轻巧便携
合香丸团队汇聚了13位从业40多年的老中医,在原方基础上反复调配、实验,送检、调整配方!每味成分都精确到毫克,多一份过剩,少一分不及!

产品使用的原材也是严格筛选!均来自专业培育药田,药用价值都远胜市面普通药材!

运用草药低温破壁技术,大大的保留原材药效!又沿袭明代古法炮制,由老师傅手工制成小丸子!只为保证更好的效果!

经过权威机构检测:成分不含任何有害化学添加,天然温和、各类人群都可以放心吃!

外包装设计更是贴心!小小一瓶放在哪里都不占空间,随时随地帮你清新口气!趁着活动多备几瓶!绝对不会出错!

养护胃肠 根除口臭源头
溶箘除臭 满口清香 去火清热
原价:58 粉丝特价:49.9元
限时买2送1、买3送2,超值!
点击下方,立即抢购
扫码关注“小来生活馆”公众号
新人即可领取50元优惠券大礼包
其中5元无门槛优惠券可购买此款商品!
此外,还有超值好礼!
关注公众号回复数字“88”
抽奖免费领取牙膏一只哦!
▼点击下方名片关注▼

